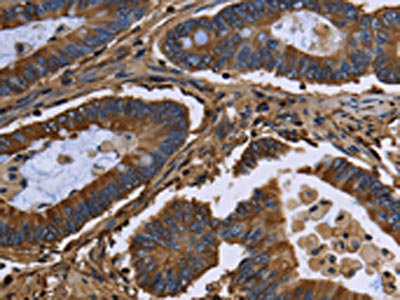

-
中文名稱:FGB兔多克隆抗體
-
貨號:CSB-PA827609
-
規格:¥1100
-
圖片:
-
The image on the left is immunohistochemistry of paraffin-embedded Human colon cancer tissue using CSB-PA827609(FGB Antibody) at dilution 1/20, on the right is treated with fusion protein. (Original magnification: ×200)
-
The image on the left is immunohistochemistry of paraffin-embedded Human cervical cancer tissue using CSB-PA827609(FGB Antibody) at dilution 1/20, on the right is treated with fusion protein. (Original magnification: ×200)
-
Gel: 6%SDS-PAGE, Lysate: 40 μg, Lane: Mouse heart tissue, Primary antibody: CSB-PA827609(FGB Antibody) at dilution 1/1000, Secondary antibody: Goat anti rabbit IgG at 1/8000 dilution, Exposure time: 5 seconds
-
-
其他:
產品詳情
-
Uniprot No.:
-
基因名:
-
別名:Beta fibrinogen antibody; Epididymis Secretory Sperm Binding Protein Li 78p antibody; FGB antibody; FIBB_HUMAN antibody; Fibrinogen beta chain antibody; Fibrinogen; B Beta Polypeptide antibody; HEL-S-78p antibody
-
宿主:Rabbit
-
反應種屬:Human,Mouse,Rat
-
免疫原:Fusion protein of Human FGB
-
免疫原種屬:Homo sapiens (Human)
-
標記方式:Non-conjugated
-
抗體亞型:IgG
-
純化方式:Antigen affinity purification
-
濃度:It differs from different batches. Please contact us to confirm it.
-
保存緩沖液:-20°C, pH7.4 PBS, 0.05% NaN3, 40% Glycerol
-
產品提供形式:Liquid
-
應用范圍:ELISA,WB,IHC
-
推薦稀釋比:
Application Recommended Dilution ELISA 1:2000-1:10000 WB 1:1000-1:5000 IHC 1:50-1:200 -
Protocols:
-
儲存條件:Upon receipt, store at -20°C or -80°C. Avoid repeated freeze.
-
貨期:Basically, we can dispatch the products out in 1-3 working days after receiving your orders. Delivery time maybe differs from different purchasing way or location, please kindly consult your local distributors for specific delivery time.
-
用途:For Research Use Only. Not for use in diagnostic or therapeutic procedures.
相關產品
靶點詳情
-
功能:Cleaved by the protease thrombin to yield monomers which, together with fibrinogen alpha (FGA) and fibrinogen gamma (FGG), polymerize to form an insoluble fibrin matrix. Fibrin has a major function in hemostasis as one of the primary components of blood clots. In addition, functions during the early stages of wound repair to stabilize the lesion and guide cell migration during re-epithelialization. Was originally thought to be essential for platelet aggregation, based on in vitro studies using anticoagulated blood. However subsequent studies have shown that it is not absolutely required for thrombus formation in vivo. Enhances expression of SELP in activated platelets. Maternal fibrinogen is essential for successful pregnancy. Fibrin deposition is also associated with infection, where it protects against IFNG-mediated hemorrhage. May also facilitate the antibacterial immune response via both innate and T-cell mediated pathways.
-
基因功能參考文獻:
- High fibrinogen expression is associated with esophageal carcinoma. PMID: 29134563
- Compared with the patients with TT genotypes of fibrinogen beta, expressions of fibrinogen, IL-6 and CRP were significantly higher in the patients with the CC and CT genotypes. PMID: 29165755
- Two novel fibrinogen Bbeta chain mutations in two Slovak families with hypofibrinogenemia/afibrinogenemia have been described. PMID: 29286337
- FGB c.490G>A indicated the activation of a cryptic splice site causing the insertion of 99 bp in intron 3. This splicing abnormality led to the production of a Bbeta-chain possessing 33 aberrant amino acids, including two Cys residues in the coiled-coil domain. Therefore, a splicing abnormality may cause impaired fibrinogen assembly and secretion. PMID: 29156616
- FGB mutations leading to congenital hypofibrinogenaemia PMID: 28306188
- Fibrinogen Bbeta448Lys variant is associated with thrombotic fibrin clots in type 2 diabetic patients independently of traditional risk factors. PMID: 27929198
- There was underexpression of the majority of genes after sunitinib treatment. The lower expression levels of IGFBP1, CCL20, CXCL6 and FGB were confirmed by qRT-PCR in all cases. The downregulation of gene expression leads us to search for methylation as a mechanism of action of the tyrosine kinase inhibitors PMID: 27834463
- elevated levels of plasma homocysteine /homocysteine thiolactone contribute to AD pathology via the Abeta-fibrin(ogen) interaction PMID: 27090576
- procoagulant changes in fibrin metastructure appear to result from excessive carbonylation of fibrinogen, which may compensate for a decrease in fibrinogen level in patients with cirrhosis PMID: 26833718
- Prognostic impact of plasma fibrinogen levels in patients with esophageal squamous cell carcinoma PMID: 28064398
- a tight cluster of alternating multiple splicing regulatory elements and U1 snRNA binding sites controls cryptic splice donor usage throughout the human fibrinogen Bbeta-chain gene (FGB) exon 7 PMID: 28039323
- The plasma fibrinogen level was found to be a possible biomarker for clinical response to chemotherapy and postoperative metastasis or death in advanced breast cancer patients who received neoadjuvant chemotherapy PMID: 28621233
- Data suggest that, in the binding of fibrin beta N-domains and the (1-8) peptide fragment of VLDLR (very low density lipoprotein receptor), the second and third Lys/Arg clusters in fibrin make major contributions to this interaction while the contribution of the first cluster is moderate. PMID: 28437098
- The novel missense mutation in the FGB gene causes afibrinogenemia most probably by affecting the secretion of the fibrinogen beta-chain. PMID: 27824214
- fibrinogen aggregation is accompanied by the formation of beta-sheet conformation, and induction of non-native helical segments in the protein inhibits aggregation PMID: 27150313
- fibrinogen is an independent predictor of the angiographic presence of coronary artery disease in hypertensive patients. PMID: 27553289
- novel mutation was identified in exon 2 of FGB caused by c.221G> T (dagger) substitution PMID: 27812779
- Our results show that higher levels of circulating chemerin, CRP, fibrinogen, and ESR are associated with an increased risk of developing colorectal cancer PMID: 26628300
- We assessed the diagnostic accuracy of a newly developed laboratory score-based on CA125, platelet count (PLT), C-reactive protein (CRP), and fibrinogen levels-in the preoperative diagnosis of adnexal mass PMID: 26499778
- the mechanical properties of individual fibrin fibers formed from blood plasma, were examined. PMID: 27028649
- Here we report a new B[beta] gene mutation (Fibrinogen St Kilda) identified in two Caucasian sisters with reduced fibrinogen level (1.2-1.6 g/L) during investigation for recurrent early miscarriages. PMID: 26308135
- desAB fibrin binds to prothrombin through the Bbeta26-42 amino acid residues and the formation of such a complex causes a non-enzymatic activation of prothrombin PMID: 26317125
- Strong positive association has been found between betatrophin, plasma fibrinogen (FBG), and insulin resistance in non-diabetic subjects. Correlations with FBG and insulin resistance were diminished in type 2 diabetes subjects. PMID: 26077345
- These experiments demonstrate, for the FGB-p.Asp185Asn mutation, a pathogenic mechanism not common for fibrinogen deficiencies, i.e. the hyperglycosylation of the Bbeta chain due to the introduction of a novel N-glycosylation motif. PMID: 26006300
- High plasma fibrinogen levels and platelet count are associated with esophageal squamous cell carcinoma. PMID: 25896470
- Results suggest that FGB -148 C/T and -854 G/A polymorphisms probably contribute to susceptibility of ischemic stroke in Chinese population. PMID: 25890854
- The results of the meta-analysis indicate that the -455 G>A polymorphism in the beta-fibrinogen gene is a susceptibility marker of ischemic cerebral infarction in the Chinese population. PMID: 25398500
- In the present study, we found that the -148C>T polymorphism in the FGB gene was significantly associated with ischemic stroke in a Chinese population [meta-analysis] PMID: 25867317
- This prospective study in 110 patients undergoing major cardiovascular surgery at risk of post-cardiopulmonary bypass bleeding compares fibrinogen level. PMID: 26011420
- the NGR motif in fibrinogen is the site that is primarily responsible for the interaction with resting alphaIIbbeta3 and is responsible for triggering platelet activation PMID: 25413489
- Elevated fibrinogen levels are associated with negative tumor response to therapy in rectal cancer. PMID: 25384698
- Four novel FGB mutations were identified in two afibrinogenemic (one new-born and one 30 years old male) and hypofibrinogenemic (a 49 years old female) patient, with heterogeneous thrombotic and bleeding phenotype PMID: 24560896
- plasma fibrinogen increase during ischemic stroke has a role in worse outcome PMID: 24531853
- meta-analysis suggests that the FGB-455G/A polymorphism contributes to susceptibility to ischemic stroke and coronary heart disease PMID: 24448059
- results of our meta-analysis suggested that the-148C>T polymorphism in the FGB gene is a susceptibility marker of ischemic stroke PMID: 24720800
- The A + genotype of the FGB -455 G/A polymorphism associated with poor survival among 55-71 years old Caucasian women in the Finnish stroke cohort. PMID: 24957141
- results indicate that FGbeta-455G/A polymorphism may be a susceptible predictor of ischemic stroke [meta-analysis] PMID: 24366241
- Elevated fibrinogen is associated with idiopathic sudden hearing loss. PMID: 24466284
- High fibrinogen levels are associated with gynecologic cancer. PMID: 25204086
- Both fibrinogen polymorphisms are capable to modify the atherosclerotic process via their effects on the coagulation cascade. PMID: 23931975
- The beta-fibrinogen -455G/A gene polymorphism is not a risk factor for ischaemic stroke in a Polish population. PMID: 23650004
- A meta-analysis of a Chinese population found that the FgB -455G/A and the -148C/T gene polymorphism was implied to be associated with coronary artery disease susceptibility. PMID: 23129316
- Both isoforms of the beta-chain of FIB discovered by 2D-gel electrophoresis are decreased in the Parkinson's disease group cerebrospinal fluid, compared to normal controls. PMID: 22889670
- Lys, as an inhibitor of protein glycation, improved fibrinogen's structure and function, both in vitro and in vivo. PMID: 22575419
- Fibrinogen polymorphisms contributes to the association between common variants in the fibrinogen gene and the risk of developing sporadic cerebral hemorrhage. PMID: 22386478
- study found that -C148T FGB polymorphism was an independent predictor of pre- and early postoperative C-reactive protein levels in coronary artery bypass graft patients PMID: 21499712
- genetic polymorphism is associated with plasma fibrinogen levels and haematological traits in whites, blacks and mexican americans PMID: 22273812
- Levels of fibrinogen and thromboelastometry fibrin polymerisation following treatment with desmopressin (DDAVP). PMID: 22293628
- The BF -455G/A polymorphisms was found to be positively. PMID: 21241403
- Fibrinogen has chaperone activity which is compromised upon glycation by methylglyoxal. PMID: 22053176
顯示更多
收起更多
-
相關疾病:Congenital afibrinogenemia (CAFBN); Dysfibrinogenemia, congenital (DYSFIBRIN)
-
亞細胞定位:Secreted.
-
組織特異性:Detected in blood plasma (at protein level).
-
數據庫鏈接:
Most popular with customers
-
YWHAB Recombinant Monoclonal Antibody
Applications: ELISA, WB, IHC, IF, FC
Species Reactivity: Human, Mouse, Rat
-
Phospho-YAP1 (S127) Recombinant Monoclonal Antibody
Applications: ELISA, WB, IHC
Species Reactivity: Human
-
-
-
-
-
-